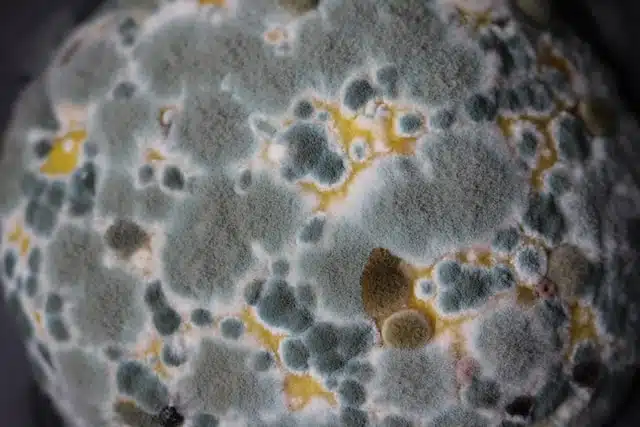

മാരകമായ ഫംഗസ് വ്യാപിക്കാന് സാധ്യതയുണ്ടെന്നും ഇവ മനഷ്യരെയും ബാധിച്ചേക്കാമെന്നും മുന്നറിയിപ്പ്. വര്ധിച്ചുവരുന്ന താപനില കാരണം ആസ്പര്ജില്ലസ് ഫംഗസ് യൂറോപ്പ്, ഏഷ്യ, അമേരിക്ക എന്നിവിടങ്ങളിലെ ചില ഭാഗങ്ങളില് വ്യാപിക്കാന് സാധ്യതയുണ്ട്. ഈര്പ്പമുള്ള കാലാവസ്ഥയില് വളരുന്ന ആസ്പര്ജില്ലസ് എന്ന ഈ ഫംഗസിന്റെ വ്യാപനം ഉണ്ടായാല് അത് ദശലക്ഷക്കണക്കിന് മനുഷ്യരെ പ്രതികൂലമായി ബാധിക്കാം. ഇത് ആളുകളില് ഗുരുതരമായ ശ്വാസകോശ സംബന്ധമായ പ്രശ്നങ്ങള്ക്ക് ഇടയാക്കിയേക്കുമെന്നും റിസര്ച്ച് സ്ക്വയറില് പ്രസിദ്ധീകരിച്ച പഠനത്തില് ചൂണ്ടിക്കാട്ടുന്നു. ഫംഗസ് രോഗങ്ങളുടെ വ്യാപനം സാധാരണമാകുന്ന ഘട്ടത്തിലേക്ക് ലോകം നീങ്ങുകയാണെന്ന് പഠനത്തിന്റെ ഭാഗമായിരുന്ന ഗവേഷകന് നോര്മന് വാന് റിന്നും മുന്നറിയിപ്പ് നല്കി. കമ്പോസ്റ്റിലെ ഉയര്ന്ന താപനിലയില് ഈ ഫംഗസുകള്ക്ക് വളരാന് സാധിക്കും. അതിനാലാണ് മനുഷ്യശരീരത്തിലെ 37°C ആന്തരിക താപനിലയില് ഇവയ്ക്ക് അതിജീവിക്കാന് സാധിക്കുന്നത് എന്ന് പഠനത്തില് പറയുന്നത്. ഈ ഫംഗസിന്റെ സ്പോറുകള് ശ്വസിക്കുന്നത് എല്ലാവരിലും ആരോഗ്യപ്രശ്നങ്ങളുണ്ടാക്കുമെന്നല്ല, മറിച്ച്, ആസ്മ, സിസ്റ്റിക് ഫൈബ്രോസിസ്, കുറഞ്ഞ രോഗപ്രതിരോധശേഷിയുള്ളവര് എന്നിവയെ രോഗം ബാധിച്ചേക്കാമെന്ന് പഠനത്തില് ചൂണ്ടിക്കാട്ടുന്നു.